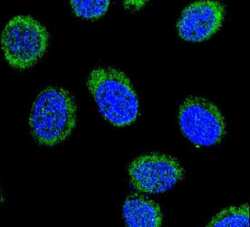

Antibody data
- Antibody Data
- Antigen structure
- References [2]
- Comments [0]
- Validations
- Immunocytochemistry [2]
- Immunohistochemistry [1]
- Flow cytometry [2]
- Other assay [3]
Submit
Validation data
Reference
Comment
Report error
- Product number
- PA5-13674 - Provider product page

- Provider
- Invitrogen Antibodies
- Product name
- SERPINC1 Polyclonal Antibody
- Antibody type
- Polyclonal
- Antigen
- Synthetic peptide
- Reactivity
- Human, Mouse
- Host
- Rabbit
- Isotype
- IgG
- Vial size
- 400 μL
- Concentration
- 1.8 mg/mL
- Storage
- Store at 4°C short term. For long term storage, store at -20°C, avoiding freeze/thaw cycles.
Submitted references Insight into the human pathodegradome of the V8 protease from Staphylococcus aureus.
Genomic structural variations lead to dysregulation of important coding and non-coding RNA species in dilated cardiomyopathy.
Frey AM, Chaput D, Shaw LN
Cell reports 2021 Apr 6;35(1):108930
Cell reports 2021 Apr 6;35(1):108930
Genomic structural variations lead to dysregulation of important coding and non-coding RNA species in dilated cardiomyopathy.
Haas J, Mester S, Lai A, Frese KS, Sedaghat-Hamedani F, Kayvanpour E, Rausch T, Nietsch R, Boeckel JN, Carstensen A, Völkers M, Dietrich C, Pils D, Amr A, Holzer DB, Martins Bordalo D, Oehler D, Weis T, Mereles D, Buss S, Riechert E, Wirsz E, Wuerstle M, Korbel JO, Keller A, Katus HA, Posch AE, Meder B
EMBO molecular medicine 2018 Jan;10(1):107-120
EMBO molecular medicine 2018 Jan;10(1):107-120
No comments: Submit comment
Supportive validation
- Submitted by
- Invitrogen Antibodies (provider)
- Main image
- Experimental details
- Immunofluorescent analysis of 293 cells using a SERPINC1 polyclonal antibody (Product # PA5-13674) at a dilution of 1:10-50, followed by a fluor-conjugated goat anti-rabbit secondary antibody (green). Nuclei were stained with DAPI (blue).
- Submitted by
- Invitrogen Antibodies (provider)
- Main image

- Experimental details
- Immunocytochemistry analysis of SERPINC1 in 293 cells. Samples were incubated in SERPINC1 polyclonal antibody (Product # PA5-13674) followed by Alexa Fluor® 488-conjugated goat anti-rabbit lgG (green). DAPI was used to stain the cell nuclear (blue).
Supportive validation
- Submitted by
- Invitrogen Antibodies (provider)
- Main image

- Experimental details
- Immunohistochemistry analysis of SERPINC1 in formalin-fixed and paraffin-embedded human hepatocarcinoma. Samples were incubated with SERPINC1 polyclonal antibody (Product # PA5-13674) which was peroxidase-conjugated to the secondary antibody, followed by DAB staining. This data demonstrates the use of this antibody for immunohistochemistry; clinical relevance has not been evaluated.
Supportive validation
- Submitted by
- Invitrogen Antibodies (provider)
- Main image

- Experimental details
- Flow cytometry analysis of HepG2 cells using a SERPINC1 polyclonal antibody (Product # PA5-13674) (right) compared to a negative control cell (left) at a dilution of 1:10-50, followed by a FITC-conjugated goat anti-rabbit antibody
- Submitted by
- Invitrogen Antibodies (provider)
- Main image

- Experimental details
- Flow cytometry of SERPINC1 in HepG2 cells (right histogram). Samples were incubated with SERPINC1 polyclonal antibody (Product # PA5-13674) followed by FITC-conjugated goat-anti-rabbit secondary antibody. Negative control cell (left histogram).
Supportive validation
- Submitted by
- Invitrogen Antibodies (provider)
- Main image

- Experimental details
- NULL
- Submitted by
- Invitrogen Antibodies (provider)
- Main image

- Experimental details
- Figure 4. Validation of V8 serum substrates identified by N-terminomics Serum was treated with varying concentrations of V8. Linear schematics depict the primary structure of proteins, with domains from UniProt/UniRef indicated. Cleavage sites inferred by N-terminomics are indicated by red markers, the scissile bond/V8 cleavage site is indicated by an asterisk with surrounding residues shown. Fragments and their ~predicted mass (calculated using ProtParam), with degradation products visible in corresponding western blots, are shown on schematics for serotransferrin, alpha-2-macroglobulin, SERPINA1, and SERPINC1. Prothrombin produced no visible degradation products; instead, the intact form and native products (produced by proteolytic activation) are depicted and visible in the untreated serum blot. AP1, activation peptide fragment 1; AP2, activation peptide fragment 2; light, thrombin light chain; heavy, thrombin heavy chain; TF1, Transferrin-like domain 1; TF2, transferrin-like domain 2; Ig, Ig-like fold; BR, bait region; RBD, receptor binding domain; RCL, reactive center loop. See also Figure S4 .
- Submitted by
- Invitrogen Antibodies (provider)
- Main image

- Experimental details
- Figure 4 Gene regulation depending on elements hit by cis - SV - eQTL s Shown is the number of regulatory genomic regions hit by SV-eQTLs leading to a positive (gray) or negative (black) gene regulation. Annotation is based the most abundant transcript per gene based on the RNA-seq data. Effect of common SVs on cardiac transcription in DCM: Shown are the gene expression levels in patients carrying a linked heterozygous SV (orange) or homozygous SV (red) in comparison with the patients not carrying the corresponding SV (green). Structural variants linked via eQTL to the cardiac gene expression of ATRX, KRT1 and SERPINC1 are frequently detected in DCM patients (9-58%). Horizontal lines represent the median normalized expression, the box limits represent the 1 st and 3 rd quartile and the error bars represent the 1.5x interquartile range. PCR-based analysis confirms the structural variant linked to KRT1 expression (see also Fig EV1 B for additionally validated SVs). Immunoblot analysis of Serpinc1 confirms increased protein levels in myocardium of a SV carrier, as predicted by the SV-eQTL. Source data are available online for this figure.